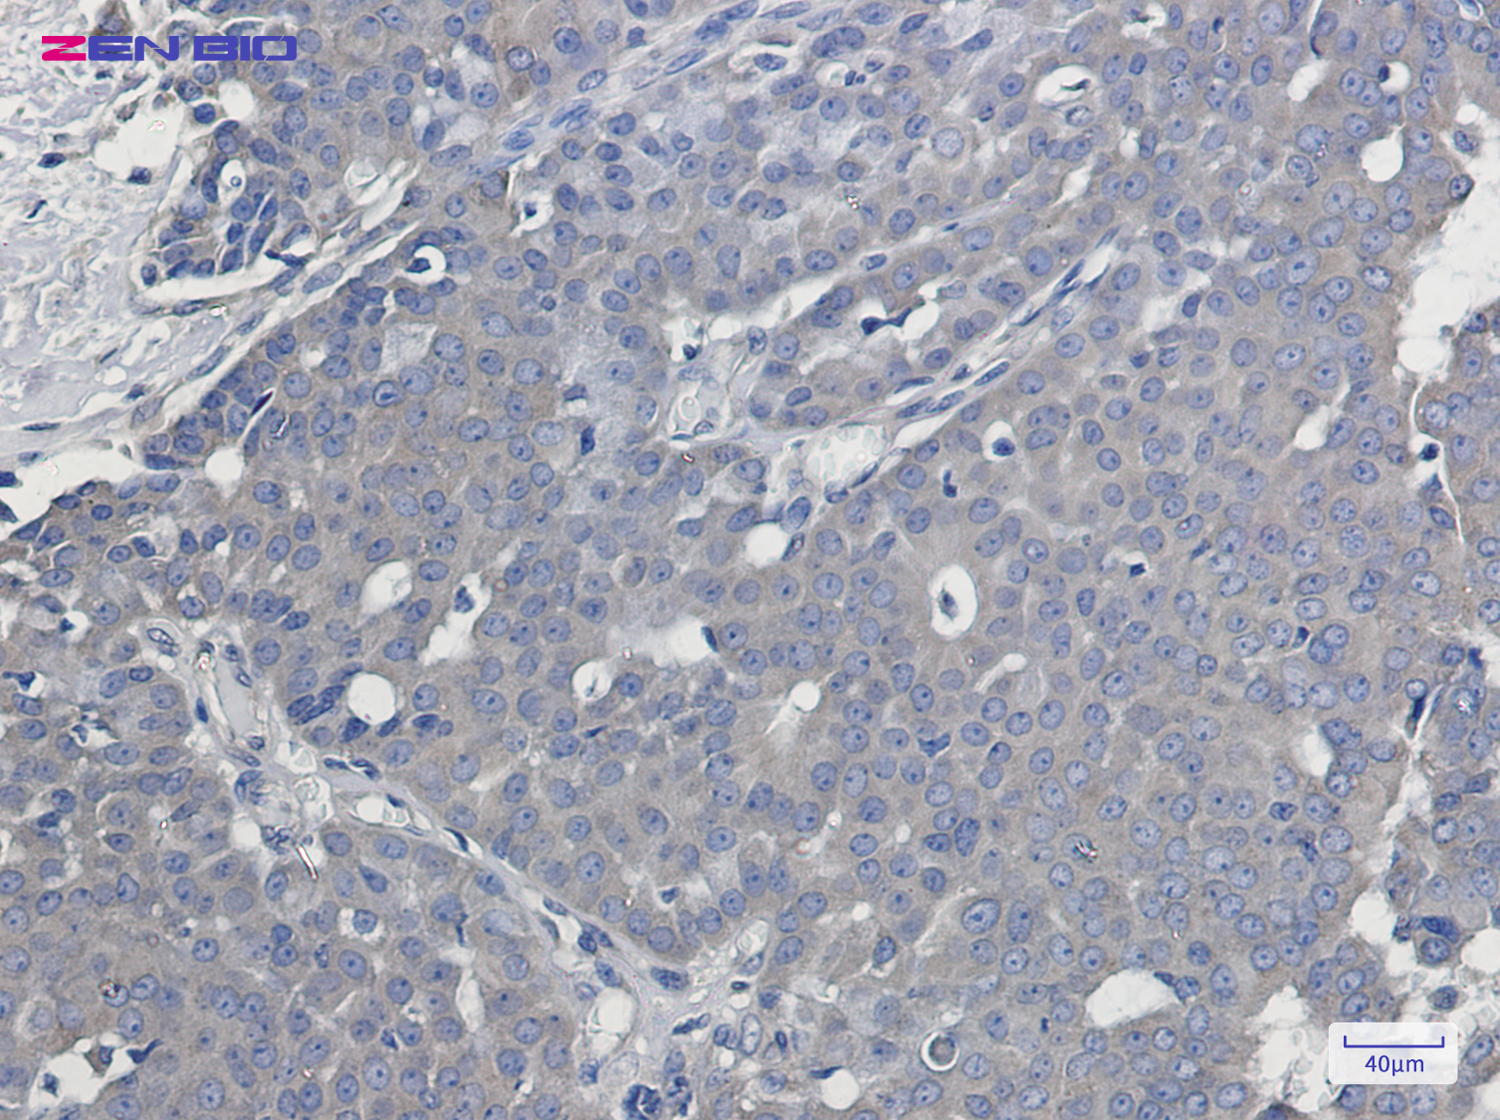
Immunohistochemistry of Syntrophin alpha 1 in paraffin-embedded Human breast cancer tissue using Syntrophin alpha 1 Rabbit pAb at dilution 1/50

-
Product Name
Anti-Syntrophin alpha 1 Rabbit antibody
- Documents
-
Description
Syntrophin alpha 1 Rabbit polyclonal antibody
-
Tested applications
WB, IHC-P, ICC/IF, FC
-
Species reactivity
Human, Mouse
-
Alternative names
SNT1; LQT12; TACIP1; dJ1187J4.5 antibody
-
Isotype
Rabbit IgG
-
Preparation
Antigen: A synthetic peptide of human Syntrophin alpha 1
-
Clonality
Polyclonal
-
Formulation
Supplied in 50nM Tris-Glycine(pH 7.4), 0.15M Nacl, 40%Glycerol, 0.01% sodium azide and 0.05% BSA.
-
Storage instructions
Store at -20°C. Stable for 12 months from date of receipt.
-
Applications
WB: 1/1000-1/5000
IHC: 1/50
ICC/IF: 1/50
FC: 1/50
-
Validations

Western blot detection of Syntrophin alpha 1 in K562 cell lysates using Syntrophin alpha 1 Rabbit pAb(1:1000 diluted).Predicted band size:54kDa.Observed band size:54kDa.
Immunohistochemistry of Syntrophin alpha 1 in paraffin-embedded Human breast cancer tissue using Syntrophin alpha 1 Rabbit pAb at dilution 1/50
-
Background
Swiss-Prot Acc.Q13424.Adapter protein that binds to and probably organizes the subcellular localization of a variety of membrane proteins. May link various receptors to the actin cytoskeleton and the extracellular matrix via the dystrophin glycoprotein complex. Plays an important role in synapse formation and in the organization of UTRN and acetylcholine receptors at the neuromuscular synapse. Binds to phosphatidylinositol 4,5-bisphosphate .
Related Products / Services
Please note: All products are "FOR RESEARCH USE ONLY AND ARE NOT INTENDED FOR DIAGNOSTIC OR THERAPEUTIC USE"
